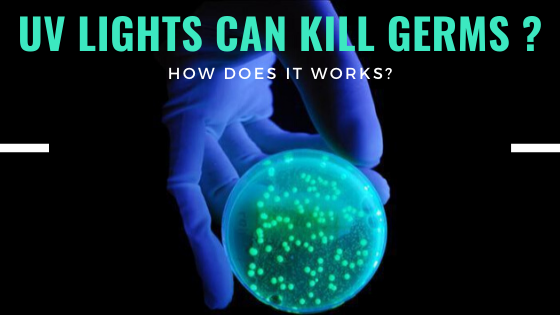

With the rising awareness of health issues, many companies released different kinds of UV sterilization products to the market, and you might be curious about how it works and does it worth trying. Let's dig in.
Which type of UV can kill germs?
In terms of UV sanitizer, not all brands of UV are applicable. For the information, ultraviolet (UV) light, also known as 'beyond the violet,' can be divided into three bands which are UVA, UVB, and UVC, with reducing wavelengths and increasing energy. When it comes to UV sanitizing, only UVC (100-280nm) has the highest power that is enough to kill microorganisms, including viruses and bacteria. So when you are deciding for UV disinfection products as a daily commodity, remember to make sure that the UV lamps' wavelength is between 100-280nm.
Click here to get more information about UV light.

How does UV kill germs?
In 1877, the research found that UVC is equipped with bactericidal effects and bacteriostatic that can kill bacteria and prevent the growth of the bacteria. Undoubtedly, UV sterilization is an invaluable and ever-growing solution that is incredibly powerful to prevent the spread of infections. In particular, the most common utilization of UV is generally associated with the medical field that helps to create a clean workspace.
For more in-depth information, the germs on the surface of the object will be killed by ultraviolet germicidal irradiation (UVGI). It is able to inactivate the microorganisms by disrupting and damaging the structure of their DNA molecules, leaving them unable to multiply and prohibiting reproduction. It is considered dead because it is no longer infectious. For your reference, the peak of DNA absorption of UV light is 260 nm, which is in the range of UVC wavelength(100-280nm). However, the germicidal UVC lamps purify up to 99% of most germs.

Will it be harmful to humans?
There is a long history of investigation that reveals, if installed correctly, the UVGI is safe and effective in the disinfection fields, which results in inhibit the transmission of a wide range of airborne infections. In the long-term, although UVC lamps can cause temporary adverse reactions to skin or eye if exposed to it directly, it never causes any permanent damage under proper installation.
What sterilization application is UV lamp applied?
Medical use - Disinfection system for different rooms in the hospital and a wide range of facilities.

Household use - UVC germicidal lamp for object surfaces sterilization and air disinfection.

Daily use - Portable UV sterilizer for disinfecting belongings everywhere and anytime.

![Lexuma XTag Apple Watch Portable Charger External Battery Power Bank [MFi certified] for Apple Watch Series 1 to 6](http://gadgeticloud.com/cdn/shop/articles/VEATOOL_Wireless_earbuds_Bluetooth_5.0_earphones_with_wireless_charging_case__5.jpg?v=1605519336&width=800)
